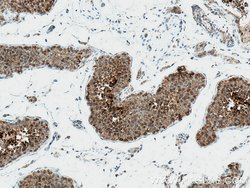
EGLN1 Mouse anti-Human, Mouse, Porcine, Rat, Clone: 1A2F1, Proteintech:Antibodies:Primary

missing translation for 'onlineSavingsMsg'
Learn More
Learn More
EGLN1 Mouse anti-Human, Mouse, Porcine, Rat, Clone: 1A2F1, Proteintech
Mouse Monoclonal Antibody
1710.33 NOK - 4836.10 NOK
Specifications
| Antigen | EGLN1 |
|---|---|
| Clone | 1A2F1 |
| Concentration | 1 mg/mL |
| Applications | Immunohistochemistry (Paraffin), Western Blot |
| Classification | Monoclonal |
| Product Code | Brand | Quantity | Price | Quantity & Availability | |||||
|---|---|---|---|---|---|---|---|---|---|
| Product Code | Brand | Quantity | Price | Quantity & Availability | |||||
|
16848605
|
Proteintech
66589-1-IG-20UL |
20 μL |
1710.33 NOK
20µL |
Please sign in to purchase this item. Need a web account? Register with us today! | |||||
|
16838605
|
Proteintech
66589-1-IG-150UL |
150 μL |
4836.10 NOK
150µL |
Please sign in to purchase this item. Need a web account? Register with us today! | |||||
Description
EGLN1 has 3 isoforms with MW of 46 kDa, 44 kDa and 36 kDa produced by alternative splicing. It mainly localizes in cytoplasm and can shuttle between the nucleus and cytoplasm. The antibody is specific to EGLN1.
SYMPK is a nuclear protein that functions in the regulation of polyadenylation and promotes gene expression. The protein forms a high-molecular weight complex with components of the polyadenylation machinery. It is thought to serve as a scaffold for recruiting regulatory factors to the polyadenylation complex. It also participates in 3′-end maturation of histone mRNAs, which do not undergo polyadenylation. The protein also localizes to the cytoplasmic plaques of tight junctions in some cell types.This gene encodes a nuclear protein that functions in the regulation of polyadenylation and promotes gene expression. The protein forms a high-molecular weight complex with components of the polyadenylation machinery. It is thought to serve as a scaffold for recruiting regulatory factors to the polyadenylation complex. It also participates in 3′-end maturation of histone mRNAs, which do not undergo polyadenylation. The protein also localizes to the cytoplasmic plaques of tight junctions in some cell types.Specifications
| EGLN1 | |
| 1 mg/mL | |
| Monoclonal | |
| Liquid | |
| RUO | |
| PBS with 50% glycerol and 0.1% sodium azide; pH 7.3 | |
| C1orf12, ECYT3, Egl nine homolog 1, EGLN1, HIF PH2, HIF prolyl hydroxylase 2, HIFPH2, HPH 2, HPH2, PHD2, PNAS 137, SM 20, SM20, ZMYND6 | |
| Egln1 | |
| IgG1 | |
| Protein G | |
| Antibody |
| 1A2F1 | |
| Immunohistochemistry (Paraffin), Western Blot | |
| Unconjugated | |
| Mouse | |
| Rat, Mouse, Human, Pig | |
| P59722, Q91YE3, Q9GZT9 | |
| 100153461, 112405, 308913, 54583 | |
| Peptide | |
| Primary | |
| -20°C | |
| EGLN1 |
Spot an opportunity for improvement?Share a Content Correction
Product Content Correction
Your input is important to us. Please complete this form to provide feedback related to the content on this product.
Product Title